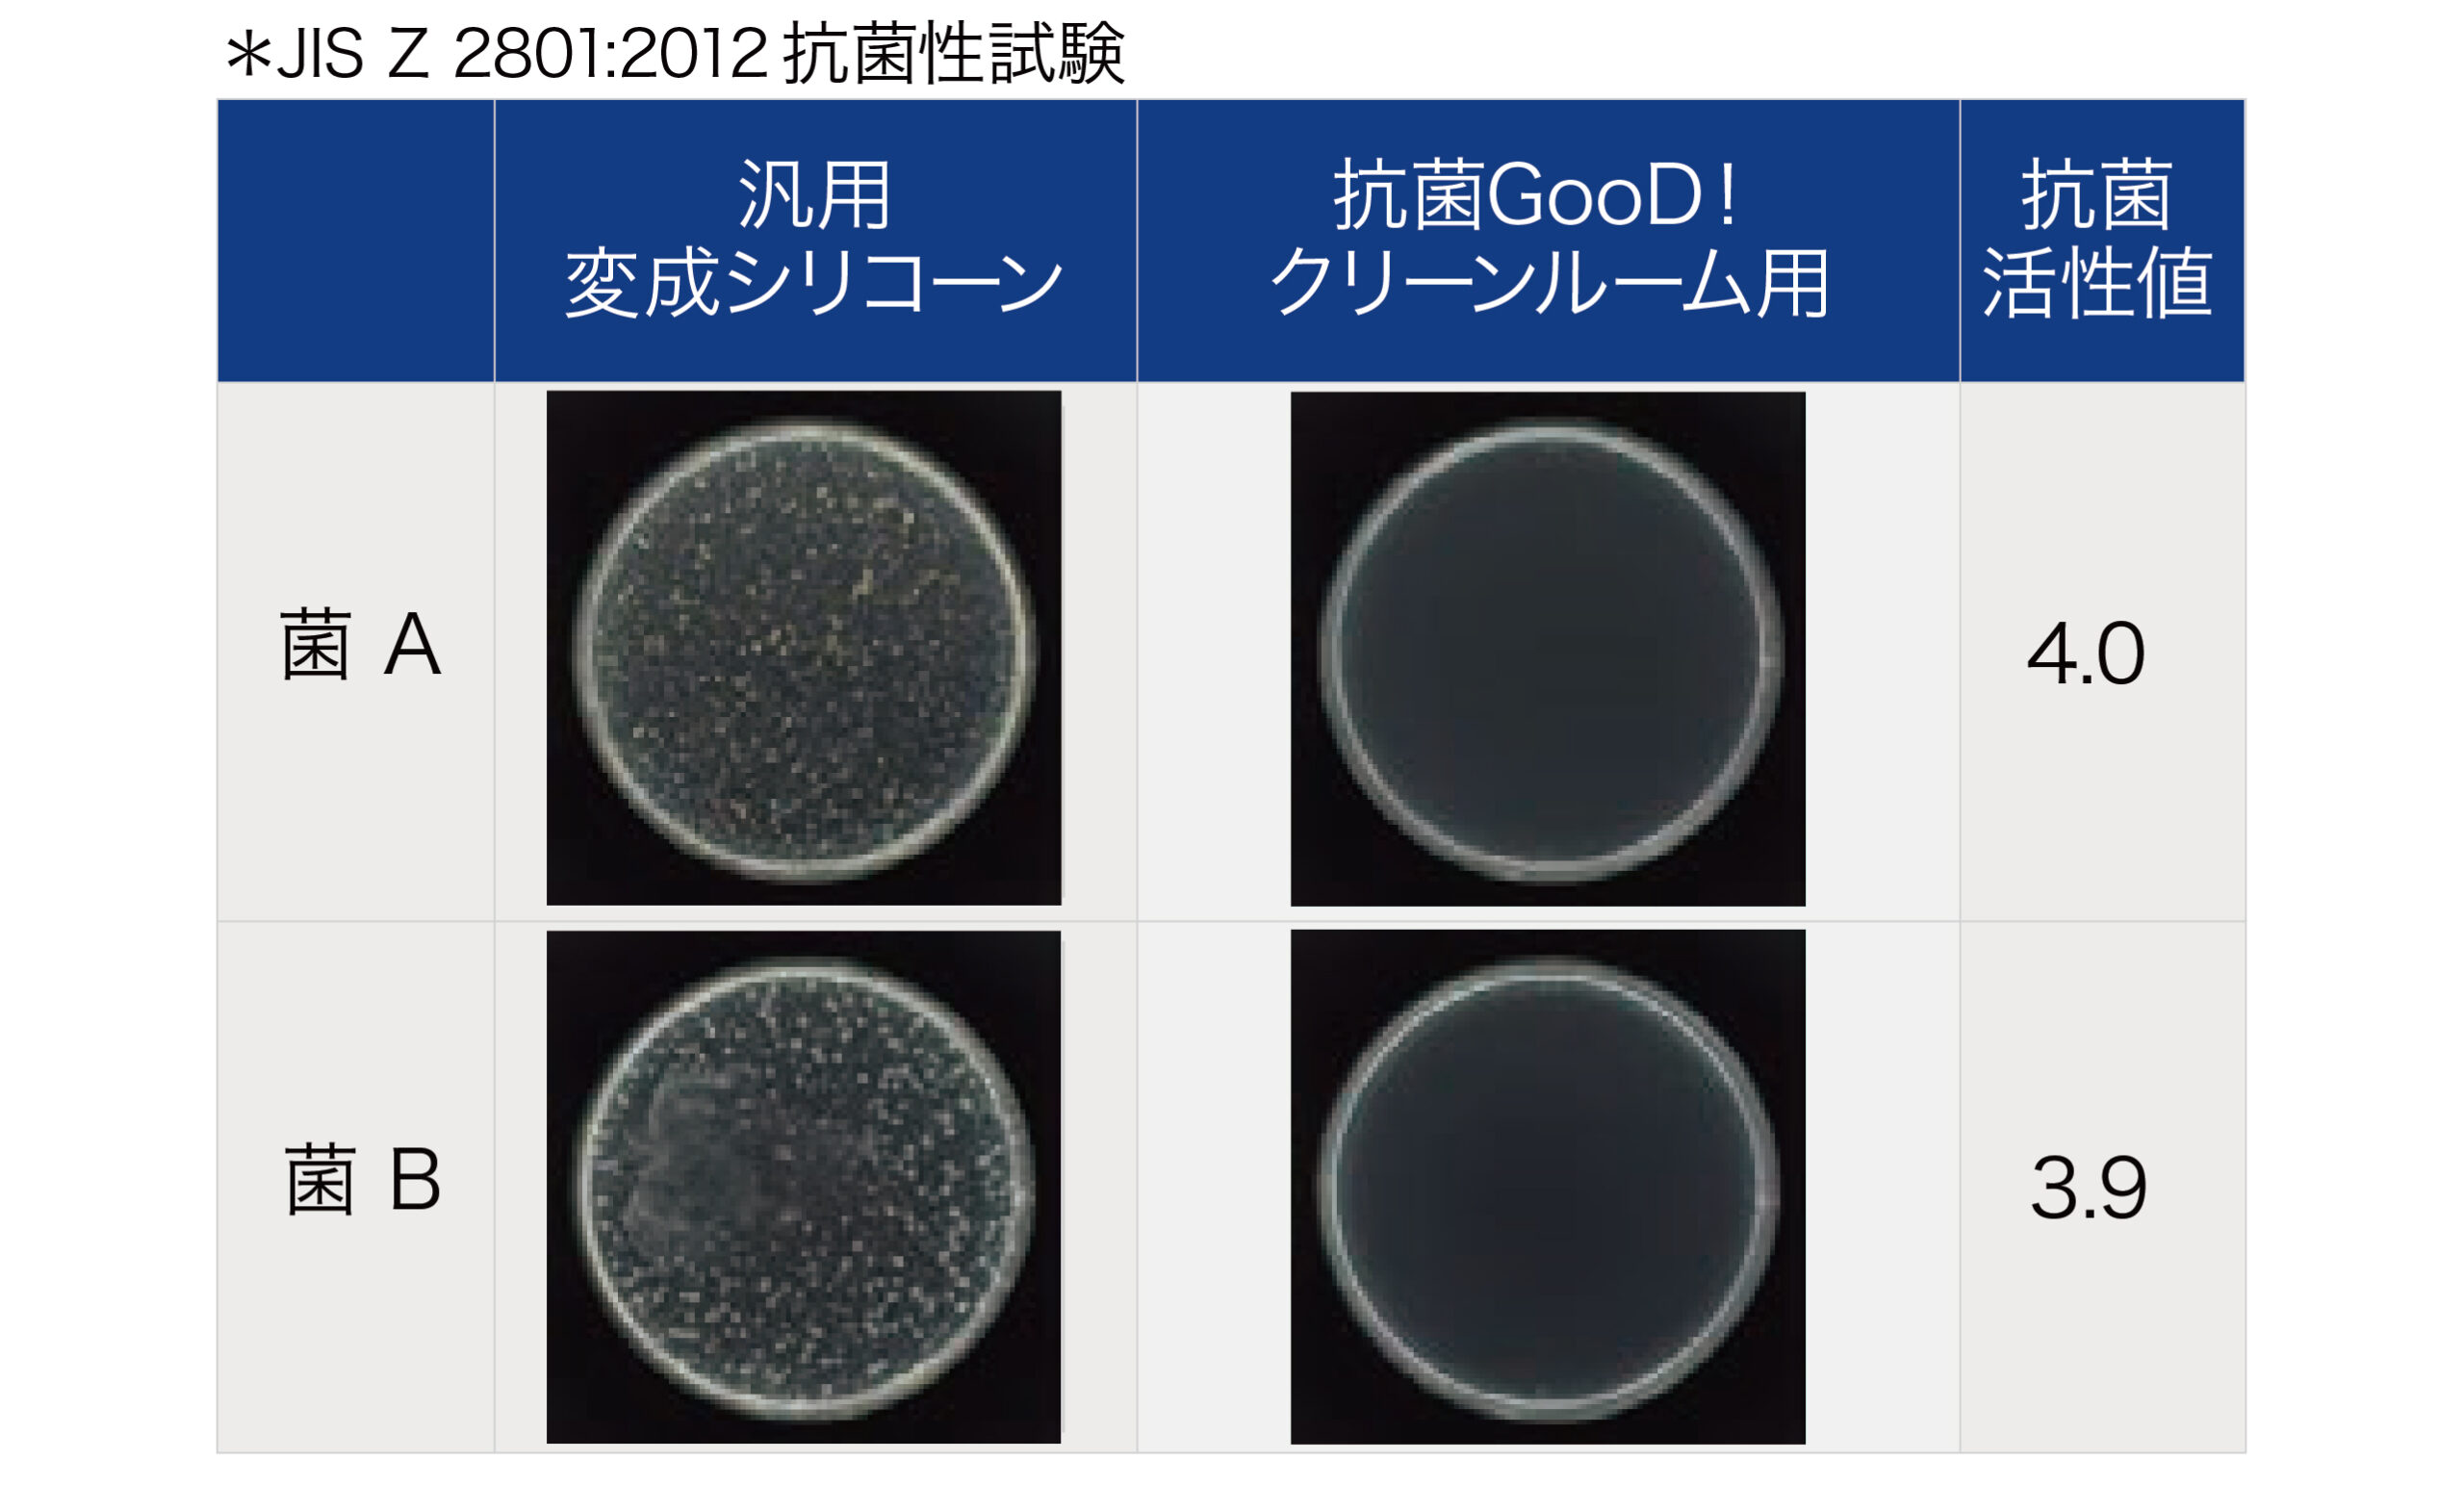

カタログのダウンロード
製品・ソリューションのお問い合わせ
抗菌GooD!クリーンルーム用
変成シリコーン系
「抗菌GooD!クリーンルーム用®」は、一般的な変成シリコーン系シーリング材の施工性・伸び・接着性といった特性を維持しつつ、電子材料への影響が懸念されるアウトガス成分の発生を抑えたシーリング材です。クリーン環境での施工に求められる性能と、高い信頼性を兼ね備えています。
【オンライン販売】
本製品はオンライン通販サイトでもご購入いただけます。
オンライン販売については、本ページ下部の「SEKISUI Plus+で購入」をご参照ください。
| 主成分 | 変成シリコーンポリマー |
|---|---|
| 外観(性状) | ペースト状 |
| 標準塗布量 | 約12-13m(φ5mm)/本 |
| 容量・形態・梱包数 |
・330ml カートリッジ×10 本入り ・320ml フィルムパック×10 本入り |
| カラー | ホワイト グレー |
抗菌GooD!クリーンルーム用のここがスゴい!!
その1
低アウトガス(検出限界以下)
電子材料を汚染する可能性のある11種のアウトガス成分について、日本空気清浄協会(JACA)が定めた指針「JACA No.34-1999(ダイナミックヘッドスペースエンジニアリングテスト法)」に基づく試験を実施。その結果、すべての成分が検出限界以下であることが確認されています。
その2
抗菌性
抗菌GooD!シリーズの中でも特に抗菌性能に優れており、清浄度の高い空間に求められる衛生性にもしっかりと対応します。
その3
施工性
一液湿気硬化タイプで、二液混合のような手間が不要。330mlの筒型カートリッジと320mlのフィルムパックの2種類を用意しており、現場ごとの作業スタイルに応じて選べます。押出性や垂れ性、硬化速度についても、施工業者の声を反映し改善された、高施工性の接着剤です。
アウトガス評価結果
試験体作製条件
シーリング材を3mm厚のシートに成形し、23℃ 50%RH環境で3日間養生した後、50×100mmに切出し、アルミパウチに密封し室温環境で6日間静置した。その後、自然環境下で1日経過させ試験片を得た。
分析方法
(JACA No.34-1999を参考に以下の方法で実施)
ガラスチャンバーに試験片を静置し、23±1℃環境下で窒素ガスを流量300ml/minの条件で60分間通気させ試験片から発生したガスを吸着管に捕集した。
その後、吸着管から有機成分を加熱離脱させ、冷却濃縮後にGC-MSを用いて各種成分の分析を実施した。各主成分の定量はトルエン換算にて算出した。

分析結果
【指定成分の定量】(単位:μg/(m2/hr)、検出限界値:3.5)

抗菌性
抗菌GooD!シリーズの特徴である、高い抗菌性能。
施工性
一液湿気硬化タイプのシーリング材であり、二液混合の手間がかかりません。また、330mlの筒型カートリッジと320mlのフィルムパックを採用し、各現場が求める包装容器に対応します。 押出性、垂れ性、硬化速度は施工業者様へのヒアリングを実施し、施工性の向上を目指しました。

取扱時の注意事項
- 取扱い時には、作業衣・保護眼鏡・保護手袋などを着用してください。
- 本製品を長時間多量に吸入すると、健康を害するおそれがあります。必ず換気をよくしてご使用ください。
- 目に入った場合は、直ちに流水で15分以上洗い流し、医師の診断を受けてください。コンタクトレンズ使用者は、できる限りコンタクトレンズを外して洗眼してください。
- 長時間、皮膚に付着したままにしないでください。すみやかに付着物を拭き取り、水と石ケンでよく洗い流してください。
- 開封後はすみやかに使い切ってください。
- 直射日光を避け、湿気の少ない冷暗所(5〜35℃)で保管してください。
- 記載の用途以外には使用しないでください。
- 本製品は使用方法・使用条件によって、本来の性能を発揮できない場合があります。事前に目的の用途に適合するかを必ず確認の上、ご使用ください。
※その他、ご不明な点は、カタログ・安全データーシート(SDS)をご参照ください。
SEKISUI Plus+で購入
抗菌GooD! クリーンルーム用は、積水マテリアルソリューションズのオンライン通販サイト「SEKISUI Plus+(セキスイプラス)」からもご購入いただけます。
SEKISUI Plus+の製品販売ページはこちら ▶ 抗菌GOOD!クリーンルーム用
